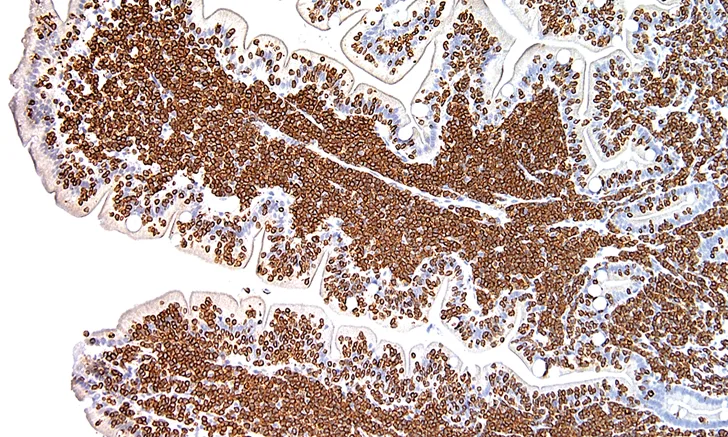

Immunodiagnostic & Immunologic Techniques
Claire L. Fellman, DVM, PhD, DACVIM (SAIM), DACVCP, Cummings School of Veterinary Medicine at Tufts University
Todd Archer, DVM, MS, DACVIM (SAIM), Mississippi State University
Tick-borne diseases such as Ehrlichia canis and Anaplasma phagocytophilum; drugs such as phenobarbital, cyclosporine, and amikacin; and thyroid hormone testing including total T4 and thyroid-stimulating hormone levels all use various types of immunoassays.
YOU HAVE ASKED...
What are the differences between antibody and antigen tests, and which test should I choose?
THE EXPERTS SAY...
There are many immunodiagnostic tests that can be used to assist in the diagnosis of infectious, endocrine, and neoplastic diseases as well as to measure blood drug concentrations (Table). This article provides a brief introduction to immunodiagnostic tests, including immunofluorescence assays, ELISAs, immunohistochemistry, and flow cytometry.
AVAILABLE IMMUNODIAGNOSTIC TESTS
Antigen:Antibody Assays
The underlying principle of immunologic testing is antigen:antibody specificity (Figure 1). Antigens are substances (often proteins or carbohydrates) capable of inciting an adaptive immune response, which often results in the production of specific antibodies.1 Adaptive immunity is the specific counterpart to innate immunity that involves the response to antigens by lymphocytes. Immunologic tests can either use antibodies to identify antigens circulating in the blood or detect patient antibodies that have formed in response to a current or previous disease.
FIGURE 1 Antigen:antibody recognition

Antigen tests such as those for feline leukemia or heartworm disease involve specific test antibodies that recognize a particular disease antigen circulating in the blood. Hormones can also be detected with antibodies, such as when testing thyroid hormone and cortisol levels. Immunoassays for cyclosporine blood concentrations and other drugs use antibodies specific to the particular drug; the amount of antibody-bound drug can then be measured to provide a quantitative assessment.
In contrast, antibody detection assays test for existing patient antibodies that recognize a particular test antigen (eg, Lyme disease, FIV). A patient’s serum is applied to the assay, and the result reflects the quantity of antibody present. These are often called serologic tests; results can be positive or negative but are often reported quantitatively as the titer of antibody present (see Serology for Infectious Diseases).
Antigen:Antibody Detection
For both antigen and antibody assays, detection methods such as fluorescence, color-linked enzyme reactions, and radioisotope labeling can be used to detect antigen:antibody complexes with varying levels of sensitivity.
Immunofluorescence assays (IFAs) involve a fluorescently labeled antibody detected with a fluorescence microscope, which increases assay sensitivity. IFA testing can be performed on blood smears or tissue sections and allows localization of the source of the positive signal.2 IFAs are commonly used to detect antibodies to infectious agents, including rickettsial organisms and Babesia spp. ELISAs involve an antibody linked to an enzyme that changes color when exposed to a substrate. Some tests provide more information than others. For example, with feline leukemia, readily available ELISA technology only tests for viral antigen in serum, which can be free or cell-associated. With an IFA, the fluorescent signal can be localized to WBCs, thus helping identify bone marrow involvement and persistent infection.
Related ArticlesTop 5 Global Vector-Borne DiseasesQuiz: Diagnostic Testing for Cancer PatientsDiagnosing Feline Hyperthyroidism
Radioisotopes are also used to label antibodies to provide more sensitive detection of low abundance targets.2 Examples of radioimmunoassays include tests for cortisol, thyroid hormones, and cyclosporine. Although radioimmunoassays have often been considered the gold standard for detecting low abundance targets such as drugs and hormones, use of other increasingly sensitive nonradioactive assays that avoid the hazards of radiation is increasing.3,4
Other immunologic methods to detect serum antibodies include the microscopic agglutination test, which is often used to detect antibodies to Leptospira spp; serum neutralization; gel immunodiffusion; and immunoblotting (or Western blotting).
The following immunoassay applications (ie, serology, immunohistochemistry, flow cytometry) can be used to determine titers for infectious disease testing, special stains for biopsy samples, and immunophenotyping.
FIGURE 2 Titer determination for serum antibodies. Various dilutions of serum are incubated on slides or in plates precoated with antigen. A detection antibody is then applied to recognize bound serum antibodies. The titer is the highest dilution of serum (ie, the most dilute serum sample) that still causes a positive test result.

Serology for Infectious Diseases
For serologic assays, the titer is the highest dilution of serum that still causes a positive response to the test (eg, fluorescent signal, color change by ELISA, positive agglutination response; Figure 2). Interpretation of titer results is dependent on characteristics of the clinical disease as well as vaccination status in some cases. A single high titer can be supportive of active infectious disease. However, problems can occur with antibody detection techniques, including positive titers that persist for months or years, depending on the agent, or antibody responses that are low early in the course of disease and require paired (ie, convalescent) titers if initial testing reveals a negative or inconclusive result.
For convalescent titers, the serologic test is repeated 2 to 4 weeks after the initial measurement. If the disease is active, a 4-fold rise in antibody titers is expected with an appropriate immune response, even if the disease is being treated appropriately.5 Convalescent titers may be necessary to confirm disease involvement. In one study involving leptospirosis, 45% of cases were considered positive only after paired titers.6
Some laboratories may optimize a particular assay for the infectious disease being tested; this releases the clinician from the challenge of deciding which type of serologic test should be performed. Finding a laboratory with appropriate quality controls and reliable results, however, is essential. For paired titers, both samples should be run at the same facility to decrease variation.
When testing for infectious disease, clinicians must determine whether serology is desired or if an agent-demonstrating technique such as antigen testing, PCR, or cytology is preferred or possible.
FIGURE 3 Photomicrograph of a feline small intestine biopsy showing diffuse CD3 staining (brown) identifying T-cell lymphoma

Immunohistochemistry
Immunohistochemistry employs antigen: antibody reactions and is used primarily by pathologists and researchers. Antibodies specific to a target of interest in the tissue are applied and detected, often using an enzymatic reaction.2 This allows pathologists to recognize certain markers in tissues, such as cytokeratin and vimentin, which identify cells of epithelial vs mesenchymal origin, respectively, and use immunohistochemistry to identify whether lymphoma is of B- or T-cell origin from a lymph node or other tissue biopsy (Figure 3). Many other specialized markers identifying specific cellular antigens can reveal further information about the tissue samples; these are the “special stains” that allow a more detailed evaluation of histopathologic biopsies.
Flow Cytometry
Flow cytometry uses antibodies to recognize antigens in a sample, but it requires cells to be suspended in a solution. Flow cytometry’s primary clinical use is for aiding in the diagnosis of hematologic disorders and malignancies. Lymph node aspirates in saline, peripheral blood, and effusions are most commonly tested. Antibodies are added to the cell suspension to identify the types of cells present. For example, CD3, CD4, and CD8 are T-cell markers, whereas CD21 indicates B cells. CD34 is a marker of immature WBCs present in acute leukemias but absent in lymphoma—a disease of fully differentiated lymphocytes. Flow cytometry, therefore, is useful to immunophenotype and characterize the particular markers on cells to determine if lymphocytes are primarily B or T; if the cells are large, small, or a mixed population; and if blast cells are present. These features help characterize the origin of the submitted cells.2
Molecular Techniques
Molecular techniques include PCR to amplify DNA and reverse-transcription PCR to detect RNA. Molecular diagnostics are reviewed in greater detail elsewhere7,8 but are briefly mentioned here as a contrast to the immunoassays described above. Although antibodies can be used to detect antigens, they are much less sensitive than PCR, and antibodies are not available for every animal pathogen. As long as the genetic sequence is known, PCR can demonstrate that an infectious organism’s DNA or RNA is present in the blood, tissue, feces, or other sample. However, because PCR assays are so sensitive, the organism detected may not always be the causative agent or be present in a quantity sufficient to induce disease. Molecular testing can also be negative if the organism is intermittently shed in the sample tested or after antimicrobial therapy if testing is performed for bacterial organisms such as Leptospira spp.
Conclusion
Immunodiagnostics employ antigen:antibody binding, with a variety of detection methods for the immune complexes formed. Antibodies can be created with a number of specificities to recognize hormones, drugs, and infectious agent antigens and antibodies. Immunoassays are often easier to perform but can be less sensitive and precise than other techniques (eg, PCR for infectious agents, chromatography for drug quantification). Immunodiagnostics are useful in infectious disease serology, for which tests are used to document antibody responses to certain pathogens. The choice of PCR vs serologic testing for an antigen or antibody depends on the stage of disease, whether an organism is expected to be present in the sample evaluated, and whether antimicrobials have been used. If serology is elected, convalescent titers are frequently needed to confirm disease presence.
IFA = immunofluorescence assay